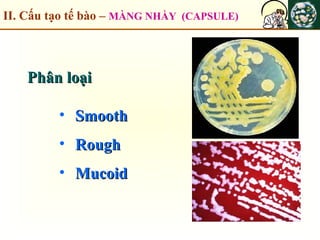
II. Cấu tạo tế bào – MÀNG NHẦY (CAPSULE)
Phân loạiPhân loại
• SmoothSmooth
• RoughRough
• MucoidMucoid

Chương 2 trình bày về hình thái, cấu tạo và sinh sản của vi khuẩn, phân chia thành hai loại chính là eubacteria và archaea, với sự khác biệt về cấu trúc tế bào và môi trường sống. Nội dung cũng đề cập đến các đặc điểm hình thái của vi khuẩn như cầu khuẩn, trực khuẩn và xoắn khuẩn, cùng với cấu trúc tế bào bao gồm thành tế bào, màng nguyên sinh chất và ribosome. Cuối cùng, chương cung cấp thông tin về quá trình sinh sản của vi khuẩn và khả năng tạo bào tử khi gặp điều kiện khắc nghiệt.